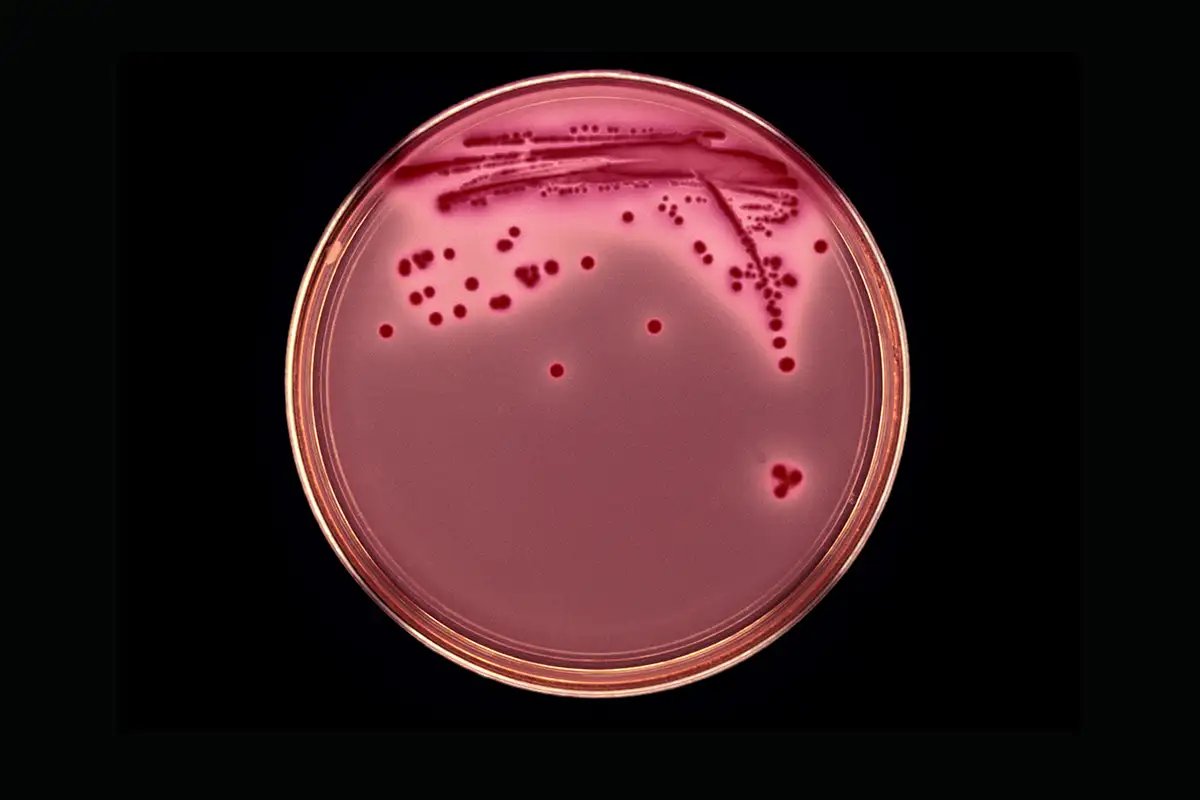
Night Sky Today tweet media

Karissa H
911 posts

Karissa H
@quantumsylph
Green traditionalist. https://t.co/NmAjdkh1zj https://t.co/TcFgEXcMnm
Great Lakes Region Katılım Mart 2025
994 Takip Edilen206 Takipçiler
Karissa H retweetledi

Collapse of key ocean current may release billions of tons of carbon
If the Atlantic Meridional Overturning Circulation shut down, the knock-on effects could release hundreds of billions of tons of CO₂, raising global temperatures even further
newscientist.com/article/252276…
docs.google.com/document/d/16P…

English
Karissa H retweetledi
Karissa H retweetledi
Karissa H retweetledi
Karissa H retweetledi

@A237844A I’m not setting off my car alarm in real life, it was a fleeting impulse that crosses my mind as darkly comedic x content that reveals something about society. I feel bad that he has no barriers between himself and the outside world, due to housing insecurity
English

@quantumsylph Homelessness is a political issue in America enveloping eviction. In other countries its an indicator of mental illness or defiance against mannerisms
English
Karissa H retweetledi
Karissa H retweetledi
Karissa H retweetledi

Cody Roberts filmed himself chasing a 9-month old female wolf on a snowmobile, laughing at her terror & exhaustion, repeatedly hitting her.
He duct-taped her mouth, brought her to a bar. For hours, people took photos as she bled to death. Then he shot her.
2 yrs probation.

ABC News@ABC
A judge in Wyoming sentenced a man to 18 months of probation for hitting a wolf with a snowmobile before taping the wounded animal's mouth shut, bringing the creature into a rural bar, then killing it. abcnews.link/6lIftx0
English